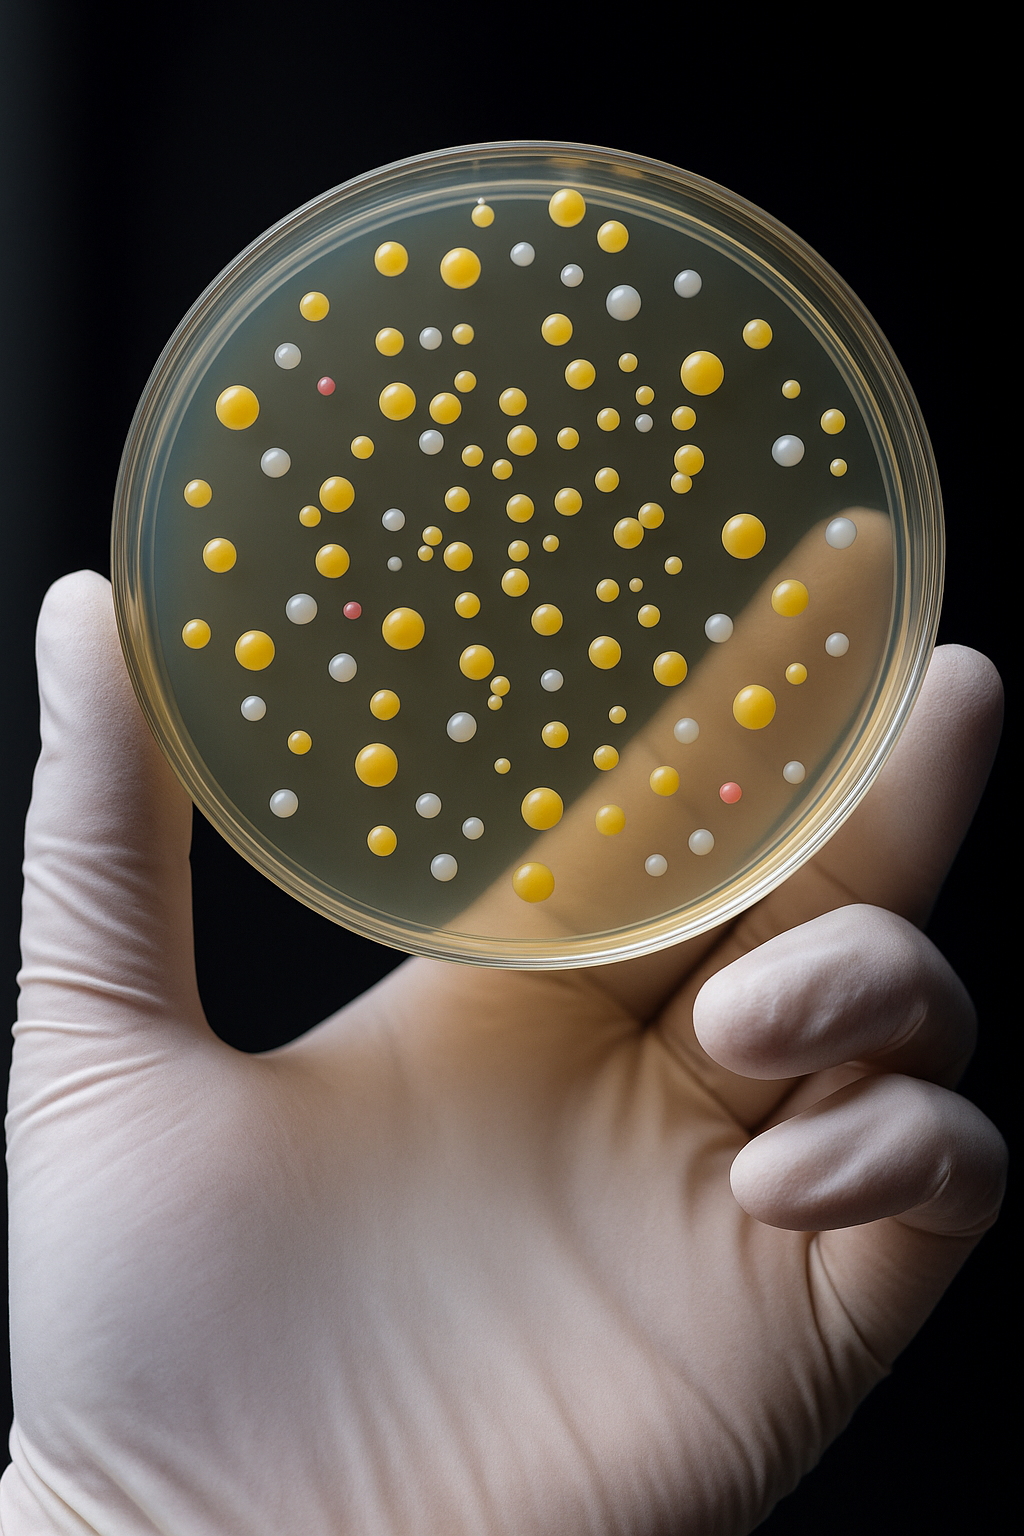

News
Seasonless Skincare: How to Keep Your Routine Balanced All Year
Your skin doesn’t stop working when the seasons change so why should your routine? From humid summers to crisp winter air, your skin’s needs shift, but the fundamentals of healthy, resilient skin remain the same. Skincare should be seasonless: a thoughtful ritual designed to adapt, protect, and perform no matter the forecast.
Learn moreThe Quiet Luxury of Texture: How Skincare Feels Is as Important as How It Works
Luxury skincare isn’t just about results; it’s about experience. From the first touch of a serum to the final glide of moisturizer, texture shapes how a product performs and how it makes you feel. We believe texture is a language of care, turning every routine into a quiet, sensorial luxury.
Learn moreThe Future of Botanicals: From Folk Remedies to Lab-Grade Actives
For centuries, cultures around the world have turned to plants, roots, and fungi for healing. From teas and tinctures to poultices and oils, these ancestral remedies laid the foundation for modern wellness. Today, science is validating what tradition has always known: botanicals hold extraordinary power for skin health. We take that knowledge one step further; elevating heritage plants through the transformative process of bio-fermentation, creating actives that are potent, stable, and proven. From Heritage to High-Performance Djon Djon MushroomOnce a Haitian delicacy, now a skincare powerhouse. Rich in minerals and adaptogens, it soothes stressed skin and supports hydration when fermented. Guava LeafTraditionally brewed as a clarifying tea, guava leaf is packed with polyphenols and vitamin C. In skincare, fermentation transforms it into stable, bioavailable compounds that defend against dullness and fatigue. Vetiver RootRevered for its grounding aroma, this root also delivers calming, restorative benefits to the skin. Fermentation enhances its soothing actives, making it ideal for barrier repair. Why Fermentation Changes Everything Fermentation doesn’t just preserve ingredients; it transforms them: Enhanced Absorption: Breaks botanicals into smaller, more bioavailable compounds. Boosted Antioxidant Power: Generates new metabolites that defend against environmental stress. Microbiome Support: Creates postbiotics that nourish skin’s natural ecosystem. The result: botanicals that are stronger, more effective, and more compatible with your skin. Where others see “clean beauty” as a trend, we see a lineage. By blending ancestral wisdom with scientific rigor, we are creating the next generation of plant-powered skincare; formulas that are not only inspired by heritage, but elevated by innovation.
Learn moreClimate-Proof Skincare: Protecting Your Barrier Through Every Season
Your skin’s needs don’t stay the same year-round. Shifts in temperature, humidity, and environmental stressors can all take a toll, leaving your complexion dry, oily, irritated, or even breakout-prone. That’s why climate-proofing your skincare isn’t about more products, but smarter ones.
Learn moreThe Science of Ritual: Why Consistency Outshines Complexity
When it comes to skincare, more isn’t always better. In fact, layering product after product can overwhelm your skin, weaken your barrier, and leave you more frustrated than glowing. The truth is, results don’t come from chasing complexity; they come from ritual.
Learn moreThe Future of Luxury Skincare Is Local
In an era where many beauty brands outsource production across the globe, Furcy Botanik takes a different path. Every formula, every bottle, every detail is crafted right here in the United States. For us, Made in the USA isn’t just a label; it’s a philosophy rooted in quality, sustainability, and transparency.
Learn moreSkinimalism: Why Fewer, Better Steps Create Stronger Skin
When it comes to skincare, more isn’t always better. From 12-step routines to product overload, the beauty industry has long celebrated “more” as the answer. But the truth is, layering too many products can overwhelm your skin, weaken its barrier, and dilute results. That’s why the new luxury in beauty isn’t about excess; it’s about skinimalism (skin minimalism).
Learn moreMicrobiome Matters: Why Balanced Skin Starts With Good Bacteria
When you think of bacteria, glowing skin may not be the first thing that comes to mind. But the truth is, your skin’s health depends on a thriving ecosystem of good bacteria; what scientists call the skin microbiome. This invisible community works around the clock to protect, repair and keep your complexion resilient. And when it’s thrown off balance? The results can show up as irritation, dryness, breakouts, or premature aging.
Learn moreUnmasking Skincare: Clean Aroma vs Synthetic Fragrance
When it comes to skincare, fragrance often gets dismissed as “just for scent.” But what if fragrance could be more than perfume in disguise? At Furcy Botanik, we believe in aroma with intention; where ingredients like vetiver root oil do more than smell good. They support the skin barrier, calm the senses, and create a ritual that feels as pure as it performs.
Learn more